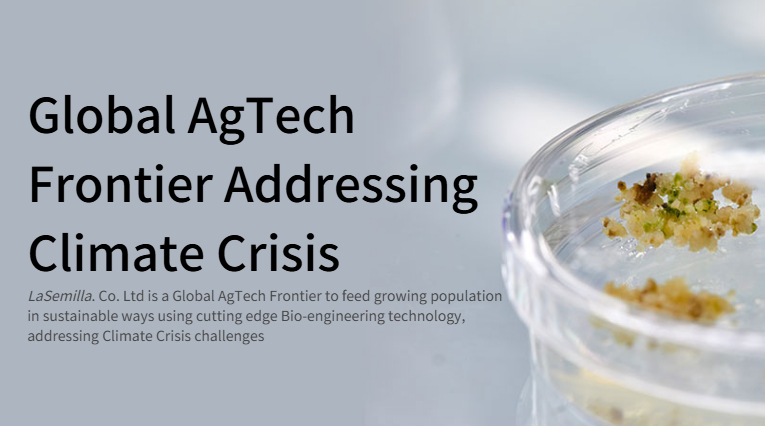

[이주의핫딜]애그테크 스타트업 라세미아, 7.5억 시리즈A 브릿지 투자유치
[스타트업에 대한 보다 다양한 기업정보는 유니콘팩토리 빅데이터 플랫폼 '데이터랩'에서 볼 수 있습니다.]


기후 변화는 단순히 지구 온도를 높이는 정도가 아니라 작물 생산량 감소에 따른 식량 위기로 이어진다. 지구촌 전역에서 농작물의 수확량이 줄고 있고, 이는 인간의 생존과 직결된 문제로 현실화하고 있다.
이 같은 위기 속에서 농업계는 GM(Genetically Modified·유전자변형) 및 GE(Genome Editing·유전자편집) 기술에 주목하고 있다. 고온, 가뭄, 염분, 병해충에 강한 작물을 만들어 기후 변화에도 안정적인 작물 생산이 가능하도록 하는 것이 이들 기술의 핵심이다.
글로벌 차원에서 다양한 애그테크(농업기술) 기업들이 GM·GE 분야에 뛰어든 가운데, 국내에서도 한 스타트업이 뛰어난 기술력을 바탕으로 두각을 나타내고 있다. 고기능성 GM·GE 종자를 개발하고 있는 '라세미아'(LaSemilla)다. 라세미아는 스페인어로 '씨앗'을 뜻한다.
라세미아의 핵심 경쟁력은 옥수수, 콩, 벼 등 다양한 작물에 적용 가능한 차세대 생명공학 형질전환 기술이다. 이 같은 뛰어난 기술력을 바탕으로 최근 한국투자액셀러레이터(한투AC)로부터 7억5000만원 규모의 시리즈A 브릿지 투자를 유치했다.
라세미아의 김주곤 대표는 서울대 국제농업기술대학원장 및 종자생명과학연구소장을 역임한 식물학자다. 국내 독보적인 생명공학 식량작물 개발 연구자로 불린다. 다수의 기업에 20건 이상을 라이센스아웃(기술이전)한 실적을 갖고 있다.
핵심 인력인 김용환 최고운영책임자(COO)는 글로벌 종자회사 '신젠타'의 대표 출신이며, 오세준 최고기술책임자(CTO)는 생명공학 작물 상업화 및 규제 전문가로 꼽힌다.
라세미아의 가뭄 저항성 기술은 식물의 BCAA(가지사슬 아미노산) 함량을 늘려 가뭄 조건에서도 일반 종자 대비 생산량을 30% 증가시킬 수 있다. 이 기술은 미국 특허 등록도 마쳤다.
또 질소 이용 효율 증진 기술은 식물의 질소 이용 유전자 발현을 촉진시켜 생산성을 유지하면서도 질소 비료 사용량을 최대 40%까지 감축할 수 있다. 이는 지구온난화 지수 측면에서 이산화탄소의 265배에 달하는 아산화질소 발생을 줄이는 데 기여한다.

한투AC는 기후 변화에 대응하는 혁신적인 종자 기술에 대한 수요가 전세계적으로 커지는 가운데, 라세미아의 기술이 실험실 수준을 넘어 글로벌 상업화가 가능한 충분한 준비가 되어 있다고 보고 이번 투자를 단행했다.
남우현 한투AC 팀장은 "라세미아의 종자 기술은 글로벌 종자회사들과 비교해도 훨씬 높은 성능을 보인다. 코르테바, 바이엘, 신젠타 같은 글로벌 종자회사들의 가뭄 시 수확량 증가율이 보통 5~12% 수준인 반면 라세미아는 30%를 달성했다"고 말했다.
독자들의 PICK!
이어 "이 분야에서 최근 가장 주목받는 기업인 바이오케레스조차 콩은 10%, 밀은 20% 수준의 수확량 증가를 보인 반면 라세미아는 포장 검증 단계에서도 30%의 견고한 성적을 보였다"고 덧붙였다.
남 팀장은 "기술이 랩(연구실)에서만 나오면 의미가 없겠지만 라세미아는 랩을 넘어서 온실 검증도 통과했고 지금은 포장 검증이라고 하는, 실환경에서의 검증까지 넘어간 단계다. 우루과이를 대표하는 대학교 및 연구재단과 함께 실증을 진행하고 있다"고 했다.

국내에선 GM·GE의 경우 규제로 인해 상업화가 어렵지만 라세미아는 우루과이와의 국제 공동 연구 협약을 통해 글로벌 시장 진출을 위한 발판을 마련했다. 라세미아는 남미 시장을 시작으로 전세계 종자 시장에 진출할 계획이다.
남 팀장은 "사람이 먹는 것은 규제가 강하기 때문에 라세미아는 한 단계 쿠션으로서 사료에 적용하는 전략을 취했다. 또 GM보다 규제가 약한 GE 기술도 보유하고 있어 규제 측면에서 소프트랜딩(연착륙)할 수 있는 강점이 있다"고 평가했다.
그러면서 "우리 생활과 가장 직결되는 옥수수, 콩, 벼 등에 적용 가능한 독자적인 기술을 가진 회사가 한국에서 나왔다는 것, 글로벌 종자회사 이상의 기술력을 만들고 있다는 것이 큰 의미가 있다"고 강조했다.
[머니투데이 스타트업 미디어 플랫폼 '유니콘팩토리']